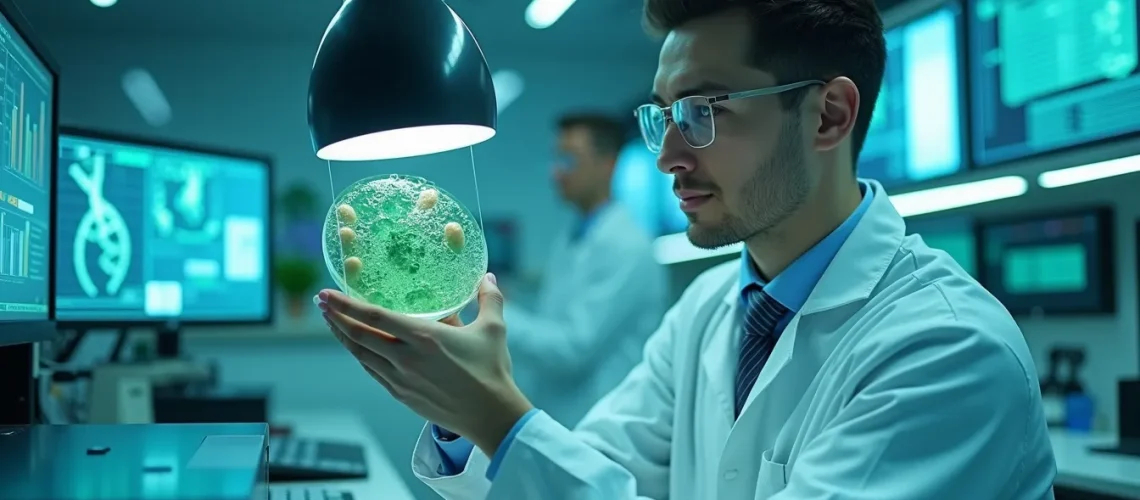
terapia celular

La búsqueda de la terapia celular adecuada para cada paciente es un desafío que requiere un enfoque analítico y personalizado. En esta guía, exploramos los aspectos esenciales que se deben considerar al elegir el tratamiento celular más adecuado para las diferentes necesidades de cada individuo. A través de un análisis detallado, ofrecemos herramientas que facilitarán esta decisión tan importante.
Factores clave para identificar la terapia celular ideal para tus necesidades
Para seleccionar la terapia celular más adecuada, es fundamental comprender las condiciones médicas específicas de cada paciente, las cuales varían dependiendo de factores como la edad, el historial médico y el estilo de vida. Por ejemplo, en el tratamiento de enfermedades degenerativas, podría ser más apropiado un enfoque regenerativo, mientras que en casos de inmunodeficiencia, se podría optar por terapias centradas en la modulación inmunológica. La identificación precisa de estas necesidades es esencial para asegurar una intervención eficaz y personalizada.
Guía completa: personalización del tratamiento celular según el perfil del paciente
La personalización del tratamiento celular es un proceso que comienza con un diagnóstico exhaustivo, seguido de un análisis cuidadoso del perfil del paciente. Este análisis incluye estudios genéticos, que permiten identificar mutaciones específicas y seleccionan terapias celulares que podrían ser más efectivas ante estas alteraciones. La investigación reciente subraya la importancia de adaptar las terapias a las características individuales, ya que un enfoque genérico rara vez proporciona los mejores resultados. La clave es la combinación de datos clínicos, genómicos y personales, para diseñar un tratamiento realmente optimizado.
Diferencias en tratamientos celulares: cómo elegir el más adecuado para cada individuo
No todas las terapias celulares ofrecen los mismos beneficios o se adaptan igualmente bien a todos los individuos. Algunas terapias pueden ser más invasivas que otras o requerir un seguimiento más cercano debido a potenciales efectos secundarios. Además, el tipo de células utilizadas, ya sean células madre adultas, embrionarias o inducidas, influye significativamente en la selección del tratamiento más adecuado. Un análisis comparativo de estas diferencias es crucial para determinar cuál terapia proporciona la mejor relación entre eficacia y seguridad para el paciente específico.
Elegir la terapia celular adecuada requiere una comprensión profunda de las necesidades particulares de cada paciente y un enfoque en la personalización del tratamiento. Factores como el diagnóstico preciso, el análisis detallado del perfil del paciente y las diferencias entre los tratamientos son vitales para tomar una decisión informada. Para obtener más información y orientación específica sobre cómo proceder con la terapia celular, lo invitamos a contactarnos y consultar nuestro servicio aquí.